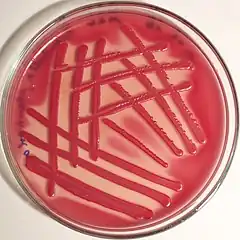
Description de cette image, également commentée ci-après

Klebsiella planticola
Klebsiella planticola
Klebsiella planticola sur gélose MacConkey, montrant un résultat positif (le microorganisme a la capacité de dégrader le lactose, ce qui est détecté par l'indicateur de pH rouge neutre). La technique de l'isolement se fait en utilisant 13 stries.
| Domaine | Bacteria |
|---|---|
| Embranchement | Proteobacteria |
| Classe | Gammaproteobacteria |
| Ordre | Enterobacteriales |
| Famille | Enterobacteriaceae |
| Genre | Klebsiella |
Espèce
Klebsiella planticola
Bagley, Seidler & Brenner, 1982
Bagley, Seidler & Brenner, 1982
Synonymes
- Raoultella planticola (Bagley, Seidler & Brenner, 1982) Drancourt et al., 2001
- Klebsiella trevisanii Ferragut, Izard, Gavini, Kersters, DeLey & Leclerc, 1983
Klebsiella planticola, un temps appelée Raoultella planticola, est une espèce de bactéries de la famille des Enterobacteriaceae. L'espèce ressemble fortement à Klebsiella pneumoniae. Parmi le genre Klebsiella, elle se distingue comme d'autres par sa production d'histamine[1].
Taxinomie
Klebsiella planticola est décrite en 1982 par Susan T. Bagley, Ramon J. Seidler et Don J. Brenner[2]. Drancourt et al. placent l'espèce dans le genre Raoultella lorsqu'ils décrivent celui-ci, sur la base de deux gènes seulement, en 2001[3],[4]. De nombreuses analyses phylogénétiques montrent par la suite que ce dernier genre est niché en plein milieu des Klebsiella et conduisent à l'abandon de ce genre[4],[3],[5],[6].
Annexes
Bibliographie
- (en) Susan T. Bagley, Ramon J. Seidler et Don J. Brenner, « Klebsiella planticola sp. nov.: A new species of enterobacteriaceae found primarily in nonclinical environments », Current Microbiology, Springer Science+Business Media, vol. 6, no 2, , p. 105-109 (ISSN 0343-8651 et 1432-0991, DOI 10.1007/BF01569013).
- (en) C. Ferragut, D. Izard, F. Gavini, K. Kersters, J. De Ley et H. Leclerc, « Klebsiella trevisanii: a new species from water and soil », International Journal of Systematic Bacteriology, vol. 33, no 2, , p. 133–142 (ISSN 0020-7713, 1465-2102 et 1070-6259, DOI 10.1099/00207713-33-2-133).
- (en) D. Monnet et J. Freney, « Method for differentiating Klebsiella planticola and Klebsiella terrigena from other Klebsiella species », Journal of Clinical Microbiology, ASM, vol. 32, no 4, , p. 1121-1122 (ISSN 0095-1137, 1098-660X et 1070-633X, OCLC 01799460, PMID 8027329, PMCID 267203, DOI 10.1128/JCM.32.4.1121-1122.1994).
Notes et références
- ↑ (en) Masashi Kanki, Tomoko Yoda, Teizo Tsukamoto et Tadayoshi Shibata, « Klebsiella pneumoniae produces no histamine: Raoultella planticola and Raoultella ornithinolytica strains are histamine producers », Applied and Environmental Microbiology, ASM, vol. 68, no 7, , p. 3462-3466 (ISSN 0099-2240, 1098-5336 et 1070-6291, PMID 12089029, PMCID 126807, DOI 10.1128/AEM.68.7.3462-3466.2002).
- ↑ Bagley, Seidler & Brenner (1982)
- 1 2 (en) Michel Drancourt, Claude Bollet, Anne Carta et Patricia Rousselier, « Phylogenetic analyses of Klebsiella species delineate Klebsiella and Raoultella gen. nov., with description of Raoultella ornithinolytica comb. nov., Raoultella terrigena comb. nov. and Raoultella planticola comb. nov. », International Journal of Systematic and Evolutionary Microbiology, Society for General Microbiology (d), vol. 51, no 3, , p. 925-932 (ISSN 1466-5026 et 1466-5034, OCLC 807119723, PMID 11411716, DOI 10.1099/00207713-51-3-925)..
- 1 2 (en) Corey M Hudson, Zachary W. Bent, Robert J. Meagher et Kelly P. Williams, « Resistance determinants and mobile genetic elements of an NDM-1-encoding Klebsiella pneumoniae strain », PLOS One, PLoS, vol. 9, no 6, , e99209 (ISSN 1932-6203, OCLC 228234657, PMID 24905728, PMCID 4048246, DOI 10.1371/JOURNAL.PONE.0099209).
- ↑ (en) Harry Thorpe, Ross Booton, Teemu Kallonen, Marjorie J. Gibbon, Natacha Couto, Virginie Passet, Juan Sebastian Lopez Fernandez, Carla Rodrigues, Louise Matthews, Sonia Mitchell, Richard Reeve, Sophia David, Cristina Merla, Marta Corbella, Carolina Ferrari, Francesco Comandatore, Piero Marone, Sylvain Brisse, Davide Sassera, Jukka Corander et Edward J. Feil, « One Health or Three? Transmission modelling of Klebsiella isolates reveals ecological barriers to transmission between humans, animals and the environment », BioRxiv, Cold Spring Harbor, CSHL, (OCLC 872278079, DOI 10.1101/2021.08.05.455249).
- ↑ (en) Marjorie J Gibbon, Natacha Couto, Sophia David, Ruth Barden, Richard Standerwick, Kishore Jagadeesan, Hollie Birkwood, Punyawee Dulyayangkul, Matthew B Avison, Andrew Kannan, Dan Kibbey, Tim Craft, Samia Habib, Harry A Thorpe, Jukka Corander, Barbara Kasprzyk-Hordern et Edward J Feil, « A high prevalence of bla OXA-48 in Klebsiella (Raoultella) ornithinolytica and related species in hospital wastewater in South West England », Microbial genomics, Society for General Microbiology (d), vol. 7, no 3, (ISSN 2057-5858, PMID 33416467, PMCID 8190614, DOI 10.1099/MGEN.0.000509).
- Portail de la microbiologie
Cet article est issu de Wikipedia. Le texte est sous licence Creative Commons – Attribution – Partage à l’identique. Des conditions supplémentaires peuvent s’appliquer aux fichiers multimédias.